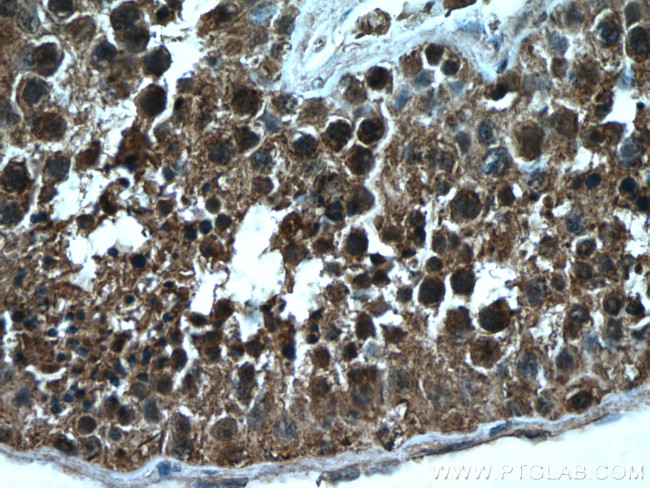
NEK2 Antibody in Immunohistochemistry (Paraffin) (IHC (P))

Search
Proteintech
NEK2 Monoclonal Antibody (3D7B4)
{{$productOrderCtrl.translations['antibody.pdp.commerceCard.promotion.promotions']}}
{{$productOrderCtrl.translations['antibody.pdp.commerceCard.promotion.viewpromo']}}
{{$productOrderCtrl.translations['antibody.pdp.commerceCard.promotion.promocode']}}: {{promo.promoCode}} {{promo.promoTitle}} {{promo.promoDescription}}. {{$productOrderCtrl.translations['antibody.pdp.commerceCard.promotion.learnmore']}}
产品信息
66632-1-IG
种属反应
宿主/亚型
分类
类型
克隆号
抗原
偶联物
形式
浓度
规格
纯化类型
保存液
内含物
保存条件
运输条件
产品详细信息
Immunogen sequence: MPSRAEDYE VLYTIGTGSY GRCQKIRRKS DGKILVWKEL DYGSMTEAEK QMLVSEVNLL RELKHPNIVR YYDRIIDRTN TTLYIVMEYC EGGDLASVIT KGTKERQYLD EEFVLRVMTQ LTLALKECHR RSDGGHTVLH RDLKPANVFL DGKQNVKLGD FGLARILNHD TSFAKTFVGT PYYMSPEQMN RMSYNEKSDI WSLGCLLYEL CALMPPFTAF SQKELAGKIR EGKFRRIPYR YSDELNEIIT RMLNLKDYHR PSVEEILENP LIADLVADEQ RRNLERRGRQ LGEPEKSQDS SPVLSELKLK EIQLQERERA LKAREERLEQ KEQELCVRER LAEDKLARAE NLLKNYSLLK ERKFLSLASN PELLNLPSSV IKKKVHFSGE SKENIMRSEN SESQLTSKSK CKDLKKRLHA AQLRAQALSD IEKNYQLKSR QILGMR (1-445 aa encoded by B C043502)
靶标信息
NEK2 is involved in cell cycle regulation and is essential for faithful chromosome segregation. NEK2 is a gene that encodes for a serine/threonine-protein kinase. This protein plays a crucial role in the regulation of mitosis and is primarily located in the centrosome. During the G1 phase, the protein is undetectable, but its levels progressively increase throughout the S phase, reaching their peak in late G2 phase. The gene has several alternatively spliced transcript variants that encode different isoforms with distinct C-termini. NEK2 is associated with several diseases, including Retinitis Pigmentosa 67 and Retinitis Pigmentosa.
仅用于科研。不用于诊断过程。未经明确授权不得转售。
生物信息学
蛋白别名: HSPK 21; NEK 2; NEK 2A; Nek2 kinase; Never in mitosis A-related kinase 2; NIMA (never in mitosis gene a)-related expressed kinase 2; NIMA (never in mitosis gene a)-related kinase 2; NIMA - related expressed kinase 2; NimA-like protein kinase 1; NIMA-related expressed kinase 2; NIMA-related kinase 2; NimA-related protein kinase 2; NLK 1; protein kinase; NIMA NEK2A-t; protein phosphatase 1, regulatory subunit 111; Serine/threonine-protein kinase Nek2; unnamed protein product
基因别名: AA617254; C77054; HsPK21; NEK2; NEK2A; NLK1; PPP1R111; RP67
UniProt ID: (Human) P51955, (Mouse) O35942
Entrez Gene ID: (Human) 4751, (Rat) 114482, (Mouse) 18005